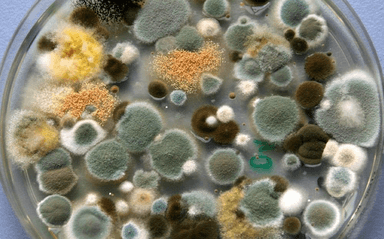
Des moisissures dans un récipient en verre

Marie-Aude Brochec


Enseignante, polyglotte et expatriée depuis dix ans en Italie, Algérie,Thaïlande et maintenant Singapour. Passionnée par la culture, Marie-Aude est également guide FOM au Indian Heritage Centre de Singapour et au Musée National de Bangkok.
Articles rédigés par Marie-Aude Brochec

SingapourPublié le 2 décembre 2025L’Impératrice électrise Singapour lors de sa tournée Pulsar World Tour 2025
Electro-pop sensuelle, disco rétro, grooves soyeux, esthétique glamour et cosmique : L’Impératrice, c’est tout cela et bien plus encore. Et Louve, Charles, Tom, David, Hagni et Achille l’ont encore démontré...
Vivre à SingapourPublié le 13 novembre 2025Raconte-moi Singapour en un objet… La pluie
“A Singapour, tu verras, il pleut tous les jours! ”. Vous avez tous entendu cette phrase à votre arrivée et, à l’usage, vous avez pu mesurer combien la pluie est une compagne quotidienne (ou presque). Capricieuse,...
Vivre à SingapourPublié le 20 octobre 2025Tout, tout, tout, vous saurez tout sur le moisi... en Asie
Singapour : la modernité, l'ordre, la propreté… et aussi une lutte quotidienne contre l'humidité et la moisissure ! Si vous venez d'emménager dans une ville en Asie du Sud-Est, il faut s'y préparer. Des amis...
Vivre à SingapourPublié le 9 octobre 2025Raconte-moi Singapour en un objet… Les conteneurs
En expatriation, ils sont souvent au cœur de nos interrogations: “A l’aide, mon container est bloqué à la douane!” Empilés avec des airs de Rubik's cube géant aux couleurs des compagnies de transport...
Vivre à SingapourPublié le 11 septembre 2025Raconte-moi Singapour en un objet… Un coq dans la ville
“Oh, regarde, il y a même des poussins!” Vous les avez forcément remarqués en vous promenant à Singapour. Dans un parc ou, plus insolite, sur le terre-plein d’un carrefour vers Cantonment Road? Ils surgissent...